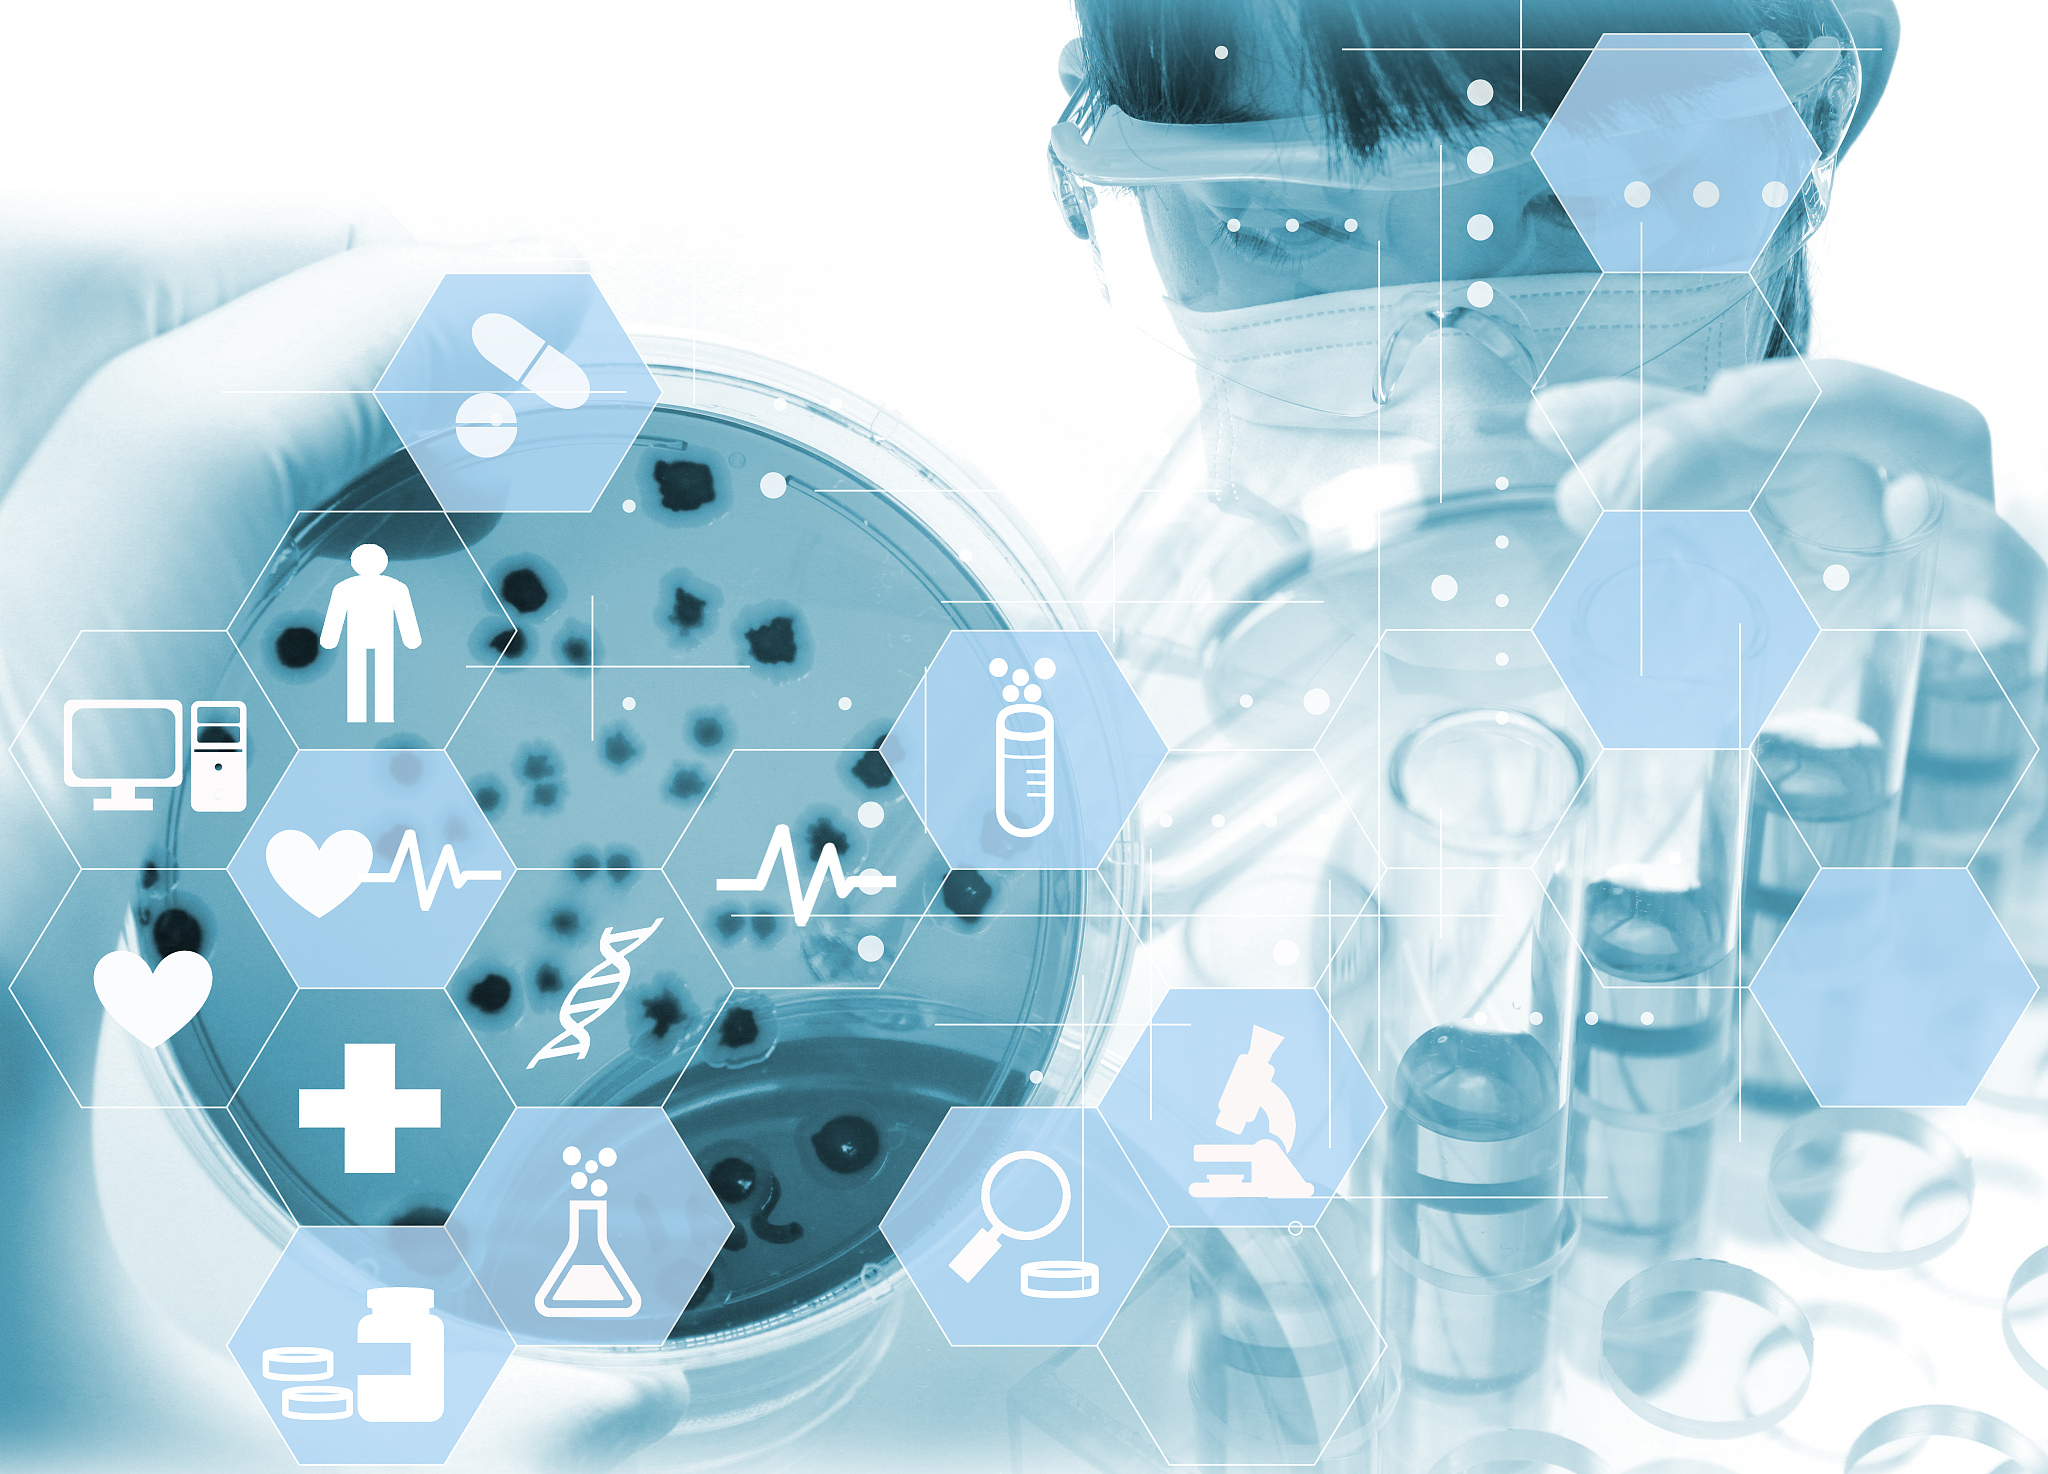
基于人工智能确定药物上市前临床时期联合用药中最佳药物剂量创新点在哪里

基于人工智能确定药物上市前临床时期联合用药中最佳药物剂量创新点在哪里
人工智能在药物研发中可以帮助确定药物上市前临床时期联合用药中最佳药物剂量的创新点。具体来说,人工智能可以通过以下方式提供创新点:
-
数据分析和挖掘:人工智能可以处理大量的临床试验数据、生物信息学数据和药物代谢动力学数据,从中挖掘出与药物剂量相关的关联性和趋势。通过对这些数据的分析,人工智能可以帮助确定药物剂量对疾病治疗效果的影响,找到最佳的剂量范围。
-
机器学习和模型优化:人工智能可以利用机器学习算法对大规模数据进行训练和建模,以预测药物剂量对治疗效果的影响。通过优化这些模型,人工智能可以找到最佳的药物剂量组合,以提高药物疗效并减少副作用。
-
药物相互作用预测:人工智能可以分析不同药物之间的相互作用,包括药物的代谢途径、药物间的相互作用和药物对特定基因的作用等。通过预测药物相互作用,人工智能可以帮助确定联合用药中最佳的药物剂量,以避免不良的相互作用和副作用。
-
个体化剂量调整:人工智能可以利用个体基因组学数据和临床特征数据,通过建立个体化的药物剂量模型,预测每个患者对药物的反应和代谢情况。通过个体化剂量调整,人工智能可以帮助确定每个患者最佳的药物剂量,以提高治疗效果和减少不良反应。
总之,基于人工智能的药物研发可以通过数据分析、机器学习、药物相互作用预测和个体化剂量调整等方法,找到药物上市前临床时期联合用药中最佳药物剂量的创新点。这些创新点可以提高药物疗效、减少副作用,并为个体化治疗提供支持。
原文地址: http://www.cveoy.top/t/topic/hSjw 著作权归作者所有。请勿转载和采集!